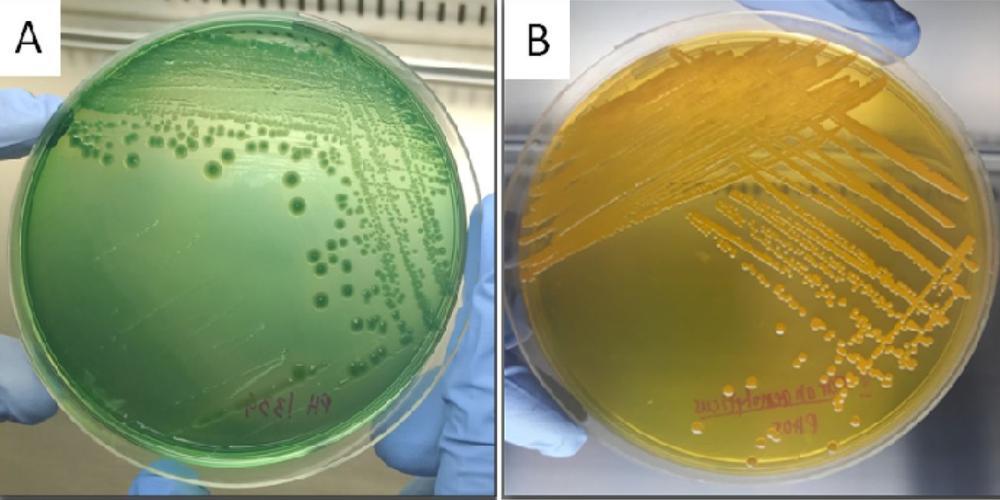
KHUẨN LẠC VÀNG HAY XANH, LỢI HAY HẠI CHO TÔM

CÔNG TY TNHH SXKD MỸ PHÚ
Với mong muốn phục vụ nhà nông ngày một tốt hơn, toàn thể ban giám đốc cũng như toàn thể nhân viên CÔNG TY TNHH SXKD MỸ PHÚ luôn học hỏi và đổi mới không ngừng, hoàn thiện từng khâu trong quá trình sản xuất, kinh doanh nhằm mang lại những sản xuất ngày một tốt hơn, chất lượng đúng theo tôn chỉ "Chất lượng là phương châm "
Với mong muốn phục vụ nhà nông ngày một tốt hơn, toàn thể ban giám đốc cũng như toàn thể nhân viên CÔNG TY TNHH SXKD MỸ PHÚ luôn học hỏi và đổi mới không ngừng, hoàn thiện từng khâu trong quá trình sản xuất, kinh doanh nhằm mang lại những sản xuất ngày một tốt hơn, chất lượng đúng theo tôn chỉ "Chất lượng là phương châm "
Với mong muốn phục vụ nhà nông ngày một tốt hơn, toàn thể ban giám đốc cũng như toàn thể nhân viên CÔNG TY TNHH SXKD MỸ PHÚ luôn học hỏi và đổi mới không ngừng, hoàn thiện từng khâu trong quá trình sản xuất, kinh doanh nhằm mang lại những sản xuất ngày một tốt hơn, chất lượng đúng theo tôn chỉ "Chất lượng là phương châm "




.png)

.png)



